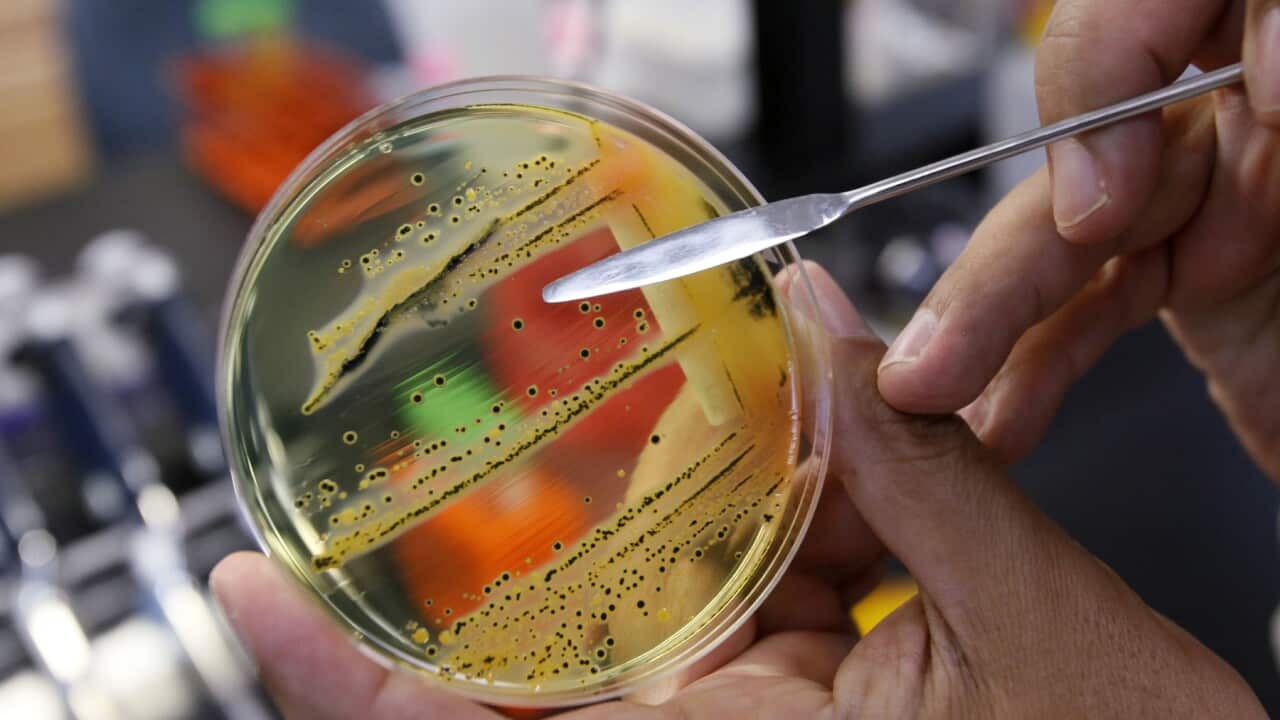
Salmonella growing in a petri dish

You can stay up to date on coronavirus in your language at sbs.com.au/coronavirus
Virus lockdowns bring some unintended consequences - not all bad
Salmonella growing in a petri dish Source: AAP
With half of the world's population now in shutdown in a bid to slow the coronavirus pandemic, many elements of normal daily are changing - and not just the things we'd expect.
Share
Recommended for you

'Descended into madness': A rare message from inside Iran lays bare an activist's fear
protests and demonstrations

Behind Trump's controversial push to acquire Greenland
trump presidency










